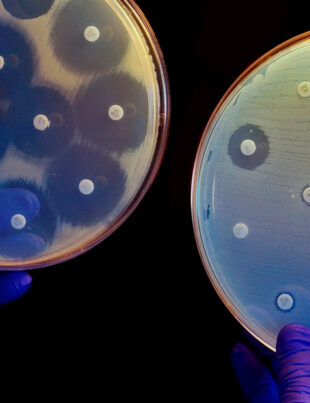

Mundo
Categorías
- Arte 1
- Atenciones prioritarias 1
- Audorio Mateo Herrera 1
- Augusto Nava Mora 1
- AUTOEMPLEO 1
- automotriz 2
- Autores guanajuatenses 1
- Avales ciudadanos 1
- bajas temperaturas 1
- Bandera Cívica del Estado de Guanajuato 1
- Beca 1
- BIBLIOTECA CENTRAL ESTATAL 1
- Boletines 418
- Buenas Prácticas Ambientales 1
- BULEVAR AEROPUERTO 1
- cabalgata de reyes magos 1
- cadena de valor 1
- CAISES 1
- CAISES Comonfort 1
- CAISES de Apaseo el Alto 1
- CAISES Villagrán 1
- cajeta 1
- CALZADO 2
- Cambiando mi Vida 1
- Campaña Invernal 2024 1
- campo 4
- Campo guanajuatense 1
- Canadá y Europa 1
- Canirac 1
- CAPACITACIÓN 7
- Carlos Diagoro Fonce Segura 1
- Carlos Martínez Assad 1
- CEA 10
- CECOSAMA 1
- Celaya 19
- Ceprereso 4
- Cercanía 1
- Ceremonia de Egreso 4
- CERESOS 1
- certamen 1
- certificación 1
- Certificaciones 1
- certificado de secundaria 1
- CESAVEG 1
- Church 4
- CICEG 1
- cifrascierre2024 1
- CIN 1
- cine 1
- círculos de estudio en Ocampo 1
- ciudad patrimonio 1
- ciudaddes patrimonio 1
- Clásicos de Guanajuato 1
- CMIC 1
- CNR 1
- CODE 3
- CODE Guanajuato 1
- COFOCE 4
- cofoce agroalimentaria 1
- Colección Alar de Arte Chino 1
- Comisión de Deporte del Estado de Guanajuato 1
- Comonfort 1
- Competitividad 3
- Complejo de Seguridad en Irapuato 1
- compra guanajuato 1
- Comunidad Educativa 2
- Comunidad Virtual 1
- comunidades rurales 1
- CONALEP 3
- Concurso 1
- conducta suicida 2
- Conectando con la Gente 2
- confeccion 1
- CONFIA 2
- Congreso “Vive sin Adicciones” 1
- Congreso del Estado 1
- consaboragto 1
- Consejo Consultivo del Sistema Estatal DIF Guanajuato 1
- Consejo Estatal de Consulta y Participación Ciudadana 1
- consejo estatal de seguridad pública 1
- Consejo Estatal Indígena del Estado de Guanajuato 1
- conservación carretera 1
- Constructoras locales 1
- Convenio Estratégico 1
- Coordinación Nacional de Teatro 1
- coro infantil 1
- Coro Monumental 1
- coro monumental de celaya 1
- Correa Ramírez 1
- CORREDOR INDUSTRIAL 1
- CREATIVIDAD 2
- Creemos en ti 1
- Cuando pase el temblor 1
- Cultura 41
- delegación de San Juan Bosco 1
- Delegación II 1
- deporte 5
- Deportistas de alto rendimiento Guanajuato 1
- Deportistas Guanajuatenses 3
- Depresión 1
- derechos humanos 2
- Derechos laborales 1
- desarrollo económico 5
- Desarrollo emocional y físico 1
- destino turístico 1
- detección oportuna 1
- DGRSA 2
- Día de la Bandera Estatal 1
- Día del Profesional de la Nutrición 2025 1
- Día Mundial de la Lepra 1
- Día Mundial de Lucha contra la Depresión 1
- DIF ESTATAL 18
- DIPLOMADO 1
- director general del INAEBA 1
- Diseño 1
- Docentes 3
- Docentes que Dejan Huella 1
- DOLORES 1
- Dolores Hidalgo 4
- Dolores Hidalgo CIN 1
- Dr. Gabriel Cortés Alcalá 1
- Dra. Elsa Cristina Flores Pérez 1
- drones 1
- Economía 21
- Economía de Guanajuato 1
- Ediciones La Rana 6
- Editoriales guanajuatenses 1
- Eduardo Arias 1
- Educación 59
- educación ambiental 1
- Educación Básica 2
- Educación de Calidad 5
- Educación Inclusiva 1
- EducAPP 1
- EDUCATIVA 1
- Eficiencia 1
- Eje Guanajuato es tranquilidad 1
- El cielo prometido y el infierno tan temido 1
- El Gobierno de la Gente 1
- El oficio del autor dramático 1
- Electricidad 1
- empleo 24
- Emprendedoras 1
- emprendedores 1
- Emprendimiento 1
- Empresas 16
- Encuentro Nacional Municipal 1
- ENERGÍA 1
- English Day 1
- entrega de apoyos 1
- Erick Silvano Montemayor Lara 1
- Ernesto Lumbreras 1
- escuchar 1
- escuelas 1
- Escuelas del Noreste 1
- Espacio E 1
- Esparza Frausto 1
- estrategia 1
- ESTUDIANte 2
- Evento 1
- Eventos 1
- excelencia en el servicio 1
- Exhibición 1
- expo ganadera león 1
- expoortacion 1
- EXPORTACION 3
- Exportaciones 3
- Exposición 1
- expportaciones 1
- FABRICA 1
- FAIS 1
- FAMILIA PRODUCTIVA Y SUSTENTABLE 1
- Featured 2
- federación 1
- Feria de León 2025 1
- Feria Internacional del Libro de Guadalajara 5
- festival 3
- Festividades 1
- fiesta 1
- fiestas 1
- Financiera de Guanajuato 1
- Financiera Tú Puedes Guanajuato 1
- Financiera y Apoyos Tú Puedes Guanajuato 1
- Finanzas 4
- FITUR 2
- fitur 2025 1
- fitur guanajuato 1
- Fondo para las Letras Guanajuatenses 1
- Foro de Derechos Humanos 1
- Fortalecen la educación 1
- FORUM CULTURAL 9
- frío 1
- FSPE 36
- fuitur 2025 1
- futuro 1
- Gabriel Cortés Alcalá 1
- ganadería 1
- ganado productivo 1
- gastronomía 1
- GENERAL MOTORS 1
- GENTE 3
- Gira de trabajo en Salamanca 1
- Gobernador de Guanajuato 1
- Gobernadora 5
- Gobernadora de Guanajuato 18
- Gobernadora de la Gente 14
- Gobernadora de laGente 1
- gobernadora guanajuato 1
- gobernadora libia 2
- gobernadora Libia Denninse García Muñoz Ledo 1
- Gobierno de Guanajuato 1
- Gobierno de la Gente 23
- gobierno del estado 16
- Gobierno del Estado de Guanajuato 1
- Gobierno Municipal 1
- Gráfica 1
- Gran Maratón Nacional de Teatro para Niñas 1
- Grupo de Ayuda Mutua 4
- Grupo de Ayuda Mutua del CAISES 1
- Grupos de Activación Física 1
- GTO 1
- Guadalupe Robles León 1
- Guanajuato 157
- guanajuato identidad 1
- Guanajuato turismo 3
- guanajuato turismo seguro 2
- Héctor Ricardo García Frausto 1
- hipertensión arterial 1
- honda 2
- Hospital Comunitario de Manuel Doblado 1
- Hospital Comunitario de San Diego de la Unión 1
- Hospital de Valle de Santiago. 1
- hoteleros 1
- iabetes mellitus 1
- IDEAGTO 1
- IDENTIDAD 5
- Identidad guanajuatense 1
- identidad guanajuato 1
- Identidad y tradiciones de Guanajuato 1
- IMCINE 1
- IMSS 1
- IMUG 2
- INAEBA 4
- Inauguración 1
- Incendios en Estados Unidos 1
- INDICADOR 1
- industria 15
- INEGI 1
- infecciones respiratorias agudas 1
- Influenza 1
- INFOSPE 1
- infraestructura 3
- INFRAESTRUCTURA EDUCATIVA 2
- INNOVACIÓN 2
- Instituto de Alfabetización y Eduación Básica para Adultos 1
- Instituto de Alfabetización y Educación Básica para Adultos 3
- Instituto de Innovación de Guanajuato 1
- Instituto Nacional de Bellas Artes y Literatura 1
- Internacional 3
- INVERSIÓN 8
- inversiones 5
- Investigación 1
- IPLANEG 2
- Irapuato 16
- ISSEG 2
- Italia 1
- itesa 1
- Itzel Balderas 1
- JAPON 1
- Jazzamoart 1
- Jerécuaro 3
- Jorge Daniel Jiménez Lona 2
- Jorge Ibargüengoitia 1
- Jorge Jiménez Lona 2
- Jornada Cultural y Deportiva Internormales 1
- José Alfredo Jiménez 1
- José Jesús Correa Ramírez 2
- José Luis Lara Valdés 1
- Juan Pablo Pérez Beltrán 12
- Jubilados y pensionados 1
- Jurisdicción Sanitaria lll 1
- Jurisdicción Sanitaria VIII 1
- Juventino Rosas 1
- JuventudEsGto 5
- K9 4
- la educación cambia vidas 1
- La página y la sombra 1
- La región de San Felipe. 1793 a 1803 y su señor cura Miguel Hidalgo 1
- La Revolución Mexicana según Jorge Ibargüengoitia 1
- La vida no vale nada 1
- Ladrilleras 1
- Las Colinas II 1
- León 126
- León Guanajuato 1
- Lepra 1
- Léxico 1
- Libia Denisse 6
- Libia Denisse García Muñoz 4
- Libia Dennise 6
- Libia Dennise García 1
- Libia Dennise García Muñoz Ledo 4
- LIBRAMIENTO 1
- Lifestyle 9
- LIZ ALEJANDRA ESPARZA FRAUSTO 1
- local 2
- logistica 1
- lograron concluir nivel educativo 1
- Los héroes no le temen al ridículo 1
- luminarias 1
- Lupita 1
- Lupita Robles 1
- Lupita Robles León 2
- Madonnari 1
- maestros 2
- Manifiesto por la Honestidad 1
- MANUFACTURA 1
- Marca GTO 1
- Marca Guanajuato 4
- marisol suárez correa 8
- Mazda 2
- medallistas guanajuatenses 1
- MEJORA REGULATORIA 1
- MEJOREDU 1
- mi barrio habla 1
- migrantes 2
- migrantes centroamericanos 1
- Miguel Alemán 1
- MINERÍA 1
- Mini Olimpiada Deportiva 1
- Mipymes 14
- moda 2
- Moroleón 2
- Muestra de emprendimiento 1
- mujeres 1
- Mundo 124
- Municipio de Apaseo El Grande 1
- municipio de Guanajuato 2
- Municipio de León 1
- Municipio de Romita 1
- Municipio de Salamanca 1
- Municipio de San Francisco del Rincón 1
- Municipios 10
- Museo Casa Diego Rivera 1
- Museo Conde Rul 1
- MUSEO ICONOGRÁFICO DEL QUIJOTE 1
- Música 2
- Nacimiento 1
- Nacional 136
- navidad 3
- NAVIDEÑO 2
- NEARSHORING 2
- Negocios 4
- News 5
- niñas 1
- niñez y la juventud 1
- Niños y Jóvenes 1
- noreste 3
- noreste de la entidad 1
- Noticias de Guanajuato 13
- noticias guanajuato 47
- Noticias Locales 1
- noticias turismo guanajauato 1
- Nuevo Comienzo 3
- Nutrición 2
- obesidad. 1
- Obra Pública 3
- OBRAS 2
- obras de infraestructura social 1
- Ocampo 2
- ondo de Aportaciones para la Infraestructura Social 1
- ONU turismo 1
- opera 1
- operativo de vigilancia sanitaria 1
- Operativo Guadalupe Reyes 2
- Operativo Peregrino 1
- Operativo Peregrino 2025 1
- Opinión 22
- oportunidades educativas 1
- orgullo 1
- orgullo guanajuatense 1
- PABELLON 1
- Pabellón Guanajuato 3
- pacientes crónicos de 1
- PAN 1
- PAOT 2
- Papiloma Humano 1
- Parque Industrial Las Colinas II 1
- Paso Inferior Vehicular Avenida Tecnológico intersección Avenida México-Japón 1
- PEC 3
- PECES 1
- películas guanajuato 1
- Pénjamo 3
- Periodo Vacacional 1
- Personal de enfermería 1
- Photo 2
- PIRELLI 1
- PLAGUICIDAS 1
- Poesía 1
- Policía Cibernética 4
- Policía Estatal de Caminos 6
- Poliforum León 1
- Política 3
- Politics 5
- Preescolar 1
- PREMIO 1
- Premio Estatal del Deporte 2024 1
- Presentación editorial 1
- presentaciones editoriales 2
- presidente municipal de Ocampo 1
- presidentes municipales 1
- Prevención 15
- Prevención de Adicciones 1
- Primera Sesión Ordinaria del Consejo Estatal Indígena del Estado de Guanajuato 2025 1
- PRODUCCION 1
- profesionalización 1
- Programa de Gobierno 1
- promotoras de salud 1
- Proni 1
- PROSPERIDAD 6
- Protección Civil 11
- Publicación 1
- Pueblo Mágico Guanajuato 1
- Pueblos del Rincón 1
- Pueblos Originarios Guanajuato 1
- Puentes Vehiculares 1
- Purísima del Rincón 5
- Recorridos guiados 1
- Red de Padres TEA 1
- Red Municipal 1
- REFUGIO 1
- REGALOS 1
- restauranteros 1
- rezago educativo 2
- riesgos clínicos 1
- Ringo Yáñez 1
- ROBOCON 1
- romita 1
- Russel Álvarez 1
- SABES 1
- saboragto 1
- Sala PAAG 1
- Salamanca 11
- SALUD 56
- Salud guanajuato 1
- Salud mental 1
- san felipe 5
- san francisco del rincón 1
- San Luis de la Paz 9
- San Luis de la Paz y la región 1
- San Miguel de Allende 4
- Santa Catarina 1
- Saraí Lepe Monjaras 1
- SDES 25
- SECAM 2
- SeCampo 7
- Secretaría de Cultura 7
- Secretaría de Derechos Humanos 2
- Secretaría de Derechos Humanos del Estado de Guanajuato 1
- Secretaría de Educación Pública (SEP 1
- secretaría de gobierno 1
- Secretaría de Gobierno del Estado de Guanajuato 2
- Secretaría de la Honestidad 1
- Secretaría de Obra Pública 5
- Secretaría de Seguridad y Paz 1
- Secretaría de Seguridad y Paz de Guanajuato 88
- Secretaría de Turismo e Identidad 1
- secretaría de turismo guanajuato 1
- SECRETARIA DEL AGUA Y MEDIO AMBIENTE 2
- secretaría del campo 1
- secretaría del campo de guanajuato 4
- secretario de educación 1
- secretario de salud 1
- Sector calzado 1
- sectur 3
- sectur gto 1
- secturi 12
- secturi guanajuato 2
- SEG 54
- Seguridad 40
- seguridad gto 1
- seguridad turismo 2
- Seguridad vial 2
- Seguridad y Paz Social 2
- SEGURO CATASTRÓFICO 1
- Semana Nacional "Compartiendo Esfuerzo 1
- sementales 1
- serie 2
- Sesión Solemne 1
- SG 4
- siembra 1
- siete 1
- siete luminarias 1
- Silao 3
- Sin categoría 67
- Sindicato Minero 1
- síntomas de la depresión 1
- síntomas de la lepra 1
- sistema de diagnostico SAAE – SAAS 1
- Sistema DIF Estatal Guanajuato 1
- Sistema Estatal DIF Guanajuato 1
- Sistema Nacional de Competencias 1
- Sistema Penitenciario 5
- SMAOT 8
- Sobrepeso 1
- SOP 12
- SSG 47
- SSG acreditó con excelencia a Grupo de Ayuda Mutua en Romita 1
- SSG afina entre los pueblos del rincón el Operativo Peregrino 2025 1
- SSG atiende más de 86 mil infecciones respiratorias en municipios cercanos a Salamanca 1
- SSG exhorta a identificar los síntomas de la depresión en la adolescencia 1
- SSG informa acciones del Día Internacional de la Eliminación de la Violencia contra las Mujeres 1
- SSG informa jornadas de vasectomías sin bisturí en Salamanca y Valle de Santiago 1
- SSG presenta a la nueva directora del Hospital de Valle de Santiago 1
- SSG sesionó en León la Red Municipal de Prevención y Atención a la Conducta Suicida 1
- SSG suma 47 nutriólogos al servicio de la población leonesa 1
- Staff's Picks 3
- STEAM Ahead 2024 1
- sueños 1
- Susana Guerra Vallejo 1
- Sustitución 1
- talento 2
- Taller 1
- TALLERES 1
- Talleres intensivos de formación continua 1
- tarimoro 1
- Teatro infantil 1
- Tecnología 2
- Temascatío 1
- templos 1
- temporada invernal 2024-2025 1
- TEQUILA 1
- terminar la primaria 1
- textil 2
- Toyota 2
- TRABAJO 3
- Trabajo entre niveles educativos 1
- tradición 1
- Trayectoria Educativa 1
- turimo segurid 1
- turimso 1
- turimso e identidad 2
- Turismo 79
- turismo cultural 1
- turismo de aventura 1
- turismo de la gente 2
- Turismo E Identidad 6
- Turismo en guanajuato 1
- turismo guanajuato 8
- turismo identidad 1
- turismo religioso guanajuato 1
- turismo seguro 2
- turismo seguro guanajuato 1
- turismo sostenible 1
- turismo yuriria 1
- turistas 1
- turistas guanajuatp 1
- Turístico 1
- Uncategorized 21
- Unidad de Transparencia del Poder Ejecutivo del Estado de Guanajuato 1
- Unidad Médica 1
- unidades médicas 1
- Uriangato 3
- USAER 1
- UTL 1
- UVEG 4
- Vacunación 1
- vacunación de COVID-19 1
- Vacunas 1
- VALLE DE SANTIAGO 3
- valor agregado 1
- Valores y Orgullo 1
- ventas 1
- VICTORIA 1
- Video 2
- vigilancia epidemiológica 1
- VIH 1
- Villagrán 1
- Villas Puentecillas 1
- Vinos 1
- violencia contra las mujeres 1
- Virus del Papiloma Humano para niñas 1
- visit mex 1
- visita Guanajuato 1
- Vitivinícola 1
- voces infantiles del MIQ 1
- Voluntariado de la Gente 1
- WER 1
- Xichú 1
- Xichú Guanajuato 1
- Yendy Cortinas 1
- Yuriria 2
- yuriria origen 1